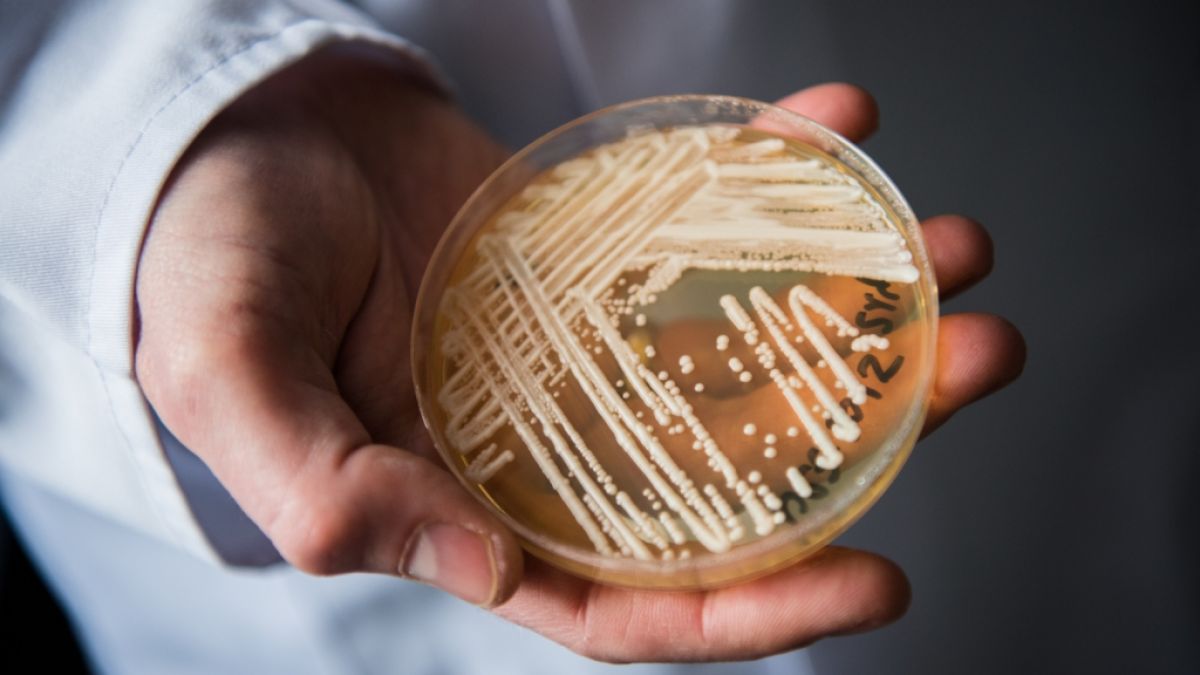
Auch in Deutschland werden immer mehr Fälle bekannt, in denen schwer kranke Patienten mit dem gefährlichen Hefepilz Candida auris infiziert sind. (Foto)

Candida auris auf dem Vormarsch: Neu entdeckter Pilz-Subtypus beunruhigt Forschende
Die sich mit steigender Tendenz ausbreitenden Infektionen mit Candida auris bereiten Forschenden Sorgen - nun wurde ein neuer Subtypus des Hefepilzes entdeckt, der die Wissenschaftsgemeinde erneut verblüfft und Fragen aufwirft.
Erstellt von Claudia Löwe - Uhr
Suche
Suche
- Candida auris auf dem Vormarsch: Fallzahlen auf steigendem Niveau
- Hefepilz breitet sich immer weiter aus - Menschen in Gesundheitseinrichtungen am stärksten gefährdet
- Neue Klade von Candida auris entdeckt: Was weiß man über den Subtypus aus Singapur?
Es sind wenig ermutigende Erkenntnisse, die Forschende in der Welt der Medizin zu einem sich immer stärker ausbreitenden Pilz gewonnen haben: Durch den Hefepilz Candida auris hervorgerufene Infektionen beschäftigen die wissenschaftliche Gemeinschaft bereits seit einigen Jahren, zumal die nachgewiesenen Fälle allein in Deutschland eine steigende Tendenz aufweisen. Ein neu aufgetauchter Typ des Hefepilzes sorgt für neue Besorgnis in der Forschungsgemeinde, wie ein Beitrag im "Focus" erklärt.
Welche Symptome hat eine Infektion mit Hefepilz Candida auris?
- Eine Infektion mit Candida auris kann sich durch verschiedene Symptome bemerkbar machen
- Im Zusammenhang mit Candida auris beschrieben wurden beispielsweise schmerzende und juckende Ohr-Infektionen, infizierte und stark gerötete Wunden sowie brennende Harnwegsinfektionen, die mit einer Trübung des Urins und verstärktem Harndrang einhergehen
- Der Hefepilz Candida auris gilt als hochgradig ansteckend und wird im zwischenmenschlichen Kontakt ebenso wie durch Schmierinfektionen übertragen
Hefepilz Candida auris zunehmend resistent gegen Medikamente - Forschende in Sorge
Besondere Sorge bereitet den Forschenden die zunehmende Resistenz des Hefepilzes gegen Medikamente, die bei Pilzinfektionen zum Einsatz kommen, sowie gegen Desinfektionsmittel. Immer häufiger müssen in der Praxis verschiedene Wirkstoffe als antimykotischer Cocktail verabreicht werden, um eine Infektion mit Candida auris in den Griff zu bekommen.
Lesen Sie hier weitere Neuigkeiten aus der Welt der Medizin:
- WHO schlägt Alarm! Diese Erreger könnten neue Pandemien auslösen
- Symptome, Warnzeichen und Therapie - das muss man zu einer Blutvergiftung wissen
- Corona-Pandemie war nichts dagegen! Angst vor schleichender Superkeim-Welle wächst
- Mittelalter-Seuche in USA bestätigt - droht uns die nächste Pandemie?
- Symptome, Warnzeichen, Erste Hilfe! Das ist bei einem Herzstillstand lebensrettend
WHO stuft potenziell resistenten Hefepilz auf Bedrohungsliste hoch
Der wissenschaftlichen Gemeinschaft sind die mit der Ausbreitung von Candida auris einhergehenden Gefahren seit geraumer Zeit bewusst, weshalb das Hauptaugenmerk nun seitens der Weltgesundheitsorganisation auf die weitere Erforschung und die Entwicklung von Vorbeugungsstrategien gelenkt wurde. Das US-amerikanische "Center for Disease Control and Prevention" sieht Candida auris bereits als ernstzunehmende "Bedrohung durch antimikrobielle Resistenz".
Diese Gefahren drohen bei einer Candida-auris-Infektion
- Von einer Infektion mit Candida auris besonderes gefährdet sind Risikopatienten wie vorerkrankte oder immunsupprimierte Personen - Krankenhäuser, Intensivstationen und Pflegeheime gelten daher als hochriskante Orte für Ausbrüche der Hefepilz-Infektionen
- Im schlimmsten Fall droht eine Sepsis infolge einer Candida-auris-Infektion, wenn der Hefepilz in den Blutkreislauf eindringt - Mediziner sprechen in einem solchen Fall von einer "Pilzsepsis"
- Der Pilz Candida auris kann nicht nur organisches Gewebe, sondern auch medizinische Hilfsmittel wie Katheter oder künstliche Gelenke befallen
Neue Klade von Candida auris in Singapur entdeckt
Ein neuer Abkömmling des Hefepilzes steht derzeit im Fokus der Forschung: Die neue Klade, die sechste bekannte für Candida auris, wurde erstmals im Jahr 2023 bei einem Patienten in einer Klinik in Singapur nachgewiesen. Im Vergleich mit anderen Erscheinungsformen des Hefepilzes ergab sich nach eingehenden Gen-Untersuchungen der Candida-auris-Probe, das sich das Probenmaterial von den fünf bisher bekannten Kladen signifikant unterschied. Während die Forschung weiter der Frage nachgeht, welche Gefahren von dem neu entdeckten Subtypus ausgehen könnte, gab es zumindest bei der Therapie einen Lichtblick: Der Candida-Pilz erwies sich als noch nicht resistent gegen derzeit verfügbare Antimyotika.
Bislang unbekannter Hefepilz-Subtyp versetzt Forschende in Sorge
Allerdings sei dies kein Grund für die Forschenden, sich entspannt zurückzulehnen: "Nachdem wir nun die sechste Candida-auris-Klade entdeckt haben, besteht dringender Bedarf, die Überwachungsmöglichkeiten zu verbessern", so der Standpunkt der Mikrobiologin Karrie Ko, die an einer im Fachjournal "The Lancet" veröffentlichten Studie zu dem in Singapur entdeckten Hefepilz mitgewirkt hat. Ebenfalls erforderlich seit die zeitnahe Entwicklung neuer Methoden, um eine effizientere Überwachung in Gesundheitseinrichtungen zu gewährleisten und so die Ausbreitung von Candida-auris-Infektionen einzudämmen.
Folgen Sie News.de schon bei WhatsApp, Facebook, Twitter, Pinterest und YouTube? Hier finden Sie brandheiße News, aktuelle Videos und den direkten Draht zur Redaktion.
loc/news.de
Erfahren Sie hier mehr über die journalistischen Standards und die Redaktion von news.de.